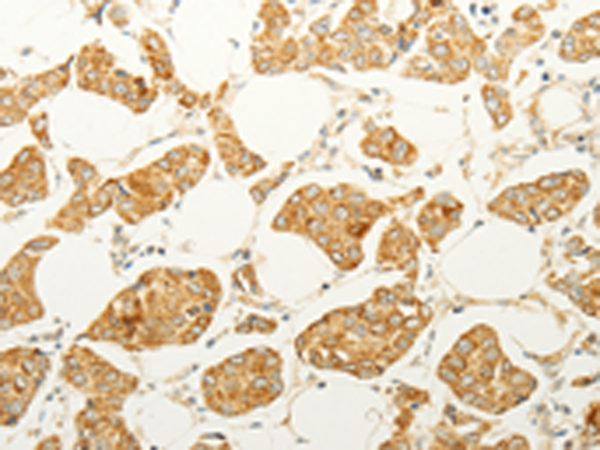

-
分类: 科研抗体货号: P07297别名: CPX, CLPA, TBXX, dJ795G23.1应用: IHC反应种属: Human
-
分类: 科研抗体货号: P07256别名:应用: IHC反应种属: Human
-
分类: 科研抗体货号: P07276别名: EFL2, EPLG3, LERK3, Ehk1-L应用: IHC反应种属: Human, Mouse
-
分类: 科研抗体货号: P07296别名: FOXN6应用: IHC反应种属: Human
-
分类: 科研抗体货号: P07253别名: DLK; FA1; ZOG; pG2; DLK-1; PREF1; Delta1; Pref-1应用: WB,IHC反应种属: Human, Mouse
-
分类: 科研抗体货号: P07275别名: B61, EFL1, ECKLG, EPLG1, LERK1, LERK-1, TNFAIP4应用: IHC反应种属: Human, Mouse, Rat
-
分类: 科研抗体货号: P07295别名: FKHL18; FREAC10应用: WB,IHC反应种属: Human, Mouse
-
分类: 科研抗体货号: P07252别名: RNF154; deltex3应用: WB反应种属: Human, Mouse
-
分类: 科研抗体货号: P07274别名: NPP6应用: IHC反应种属: Human, Mouse, Rat
-
分类: 科研抗体货号: P07294别名: HFREP1; HP-041; LFIRE1; LFIRE-1应用: WB,IHC反应种属: Human, Mouse, Rat

鄂公网安备42018502007531号
鄂公网安备42018502007531号

